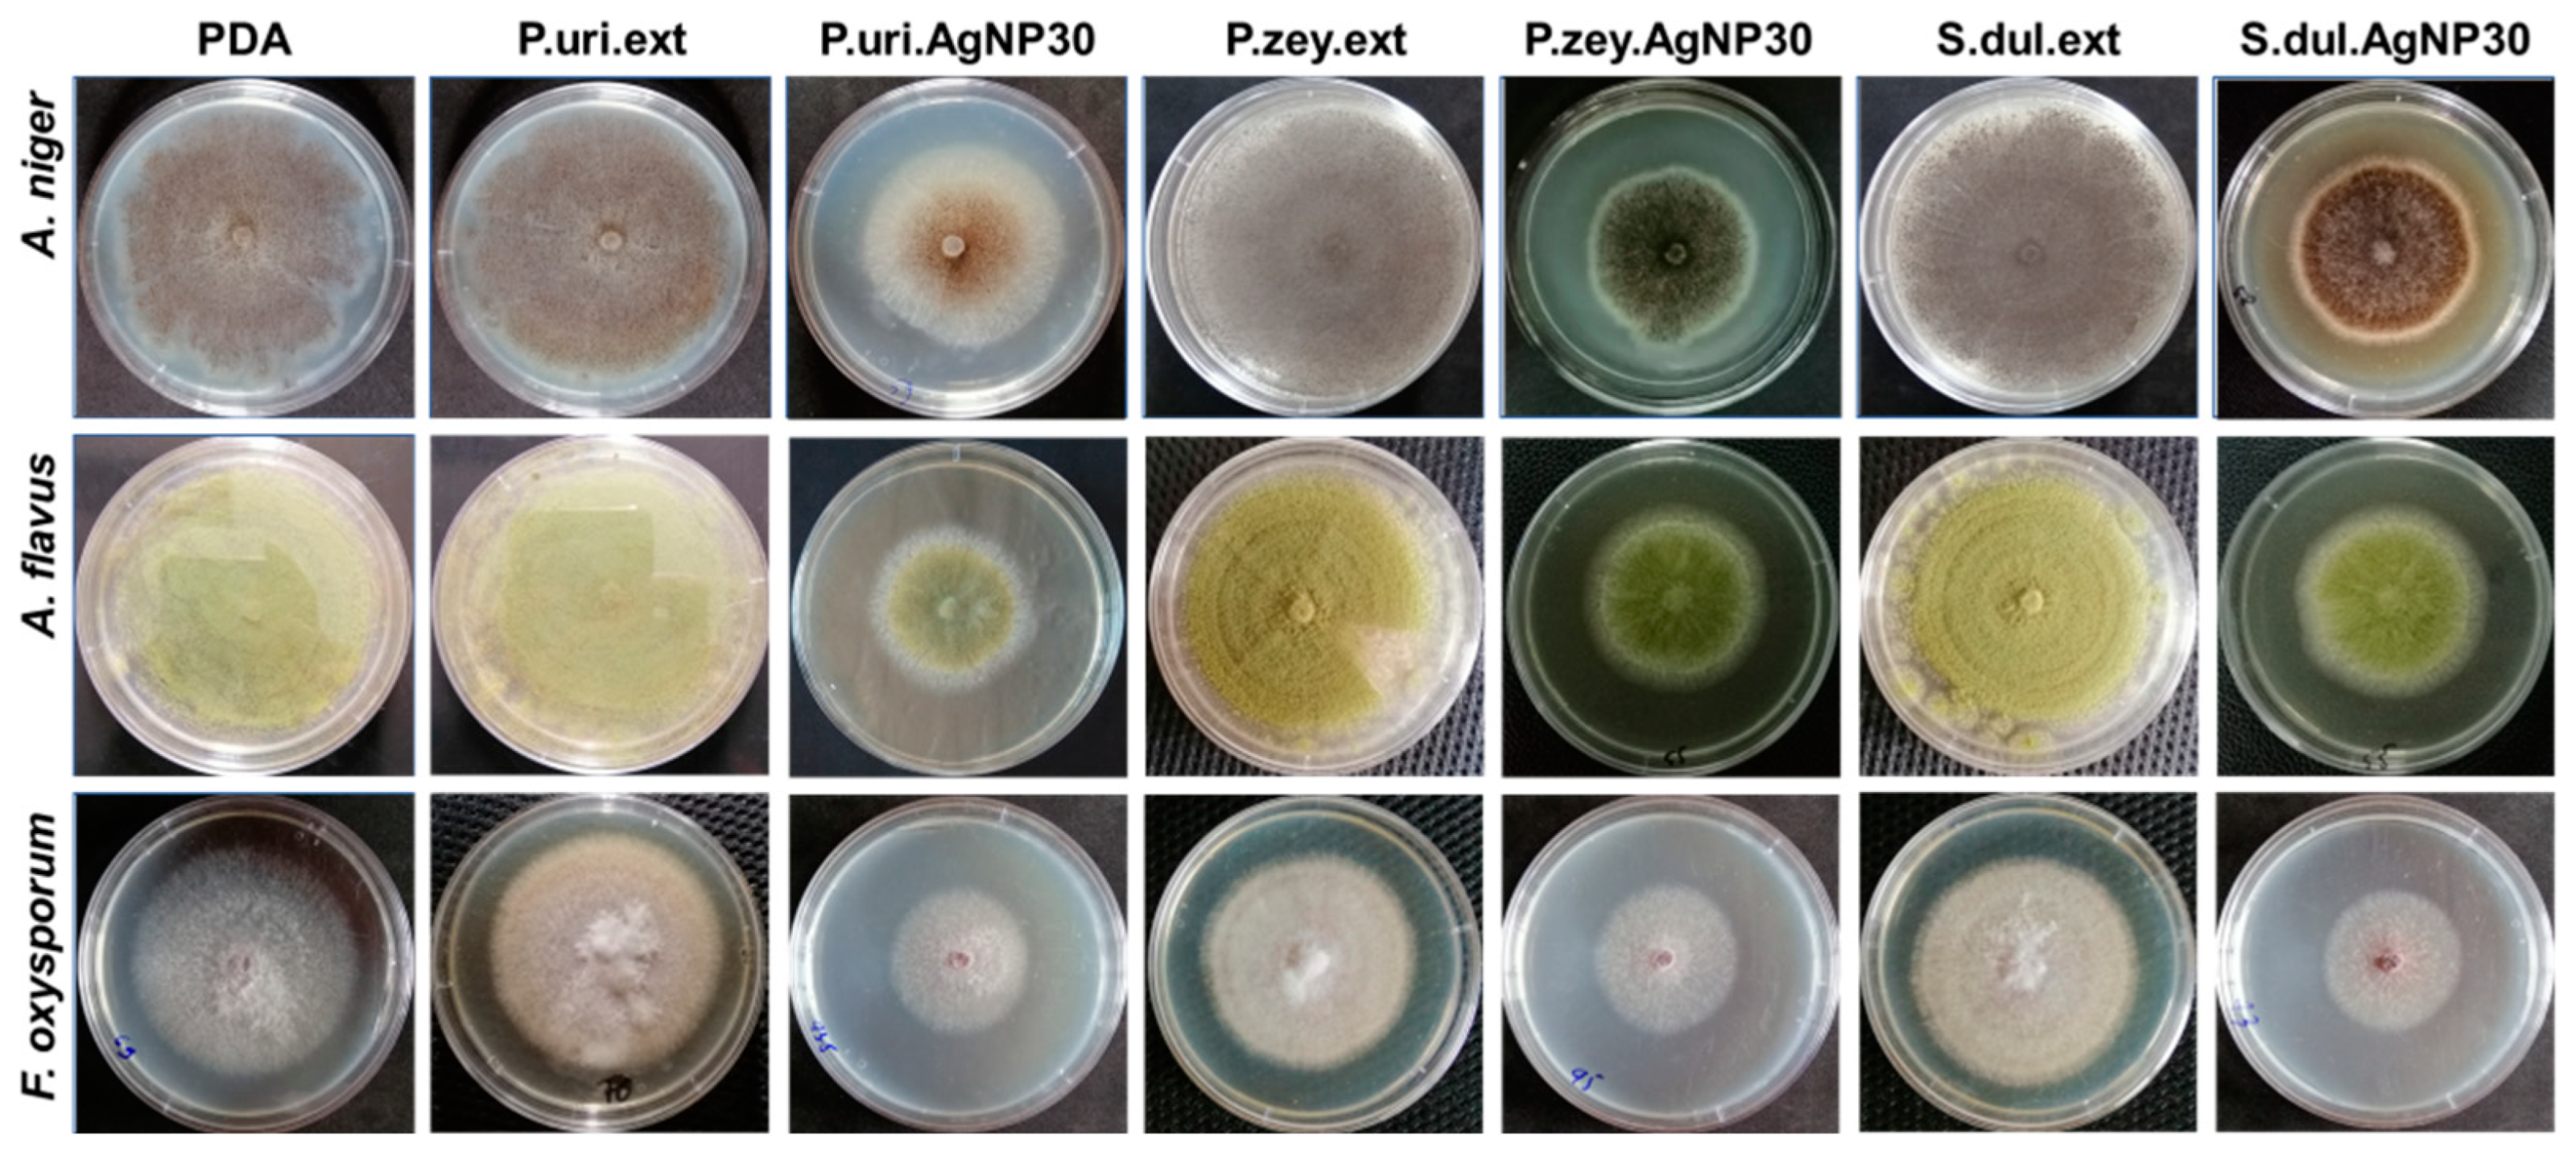
Nanomaterials 10 00542 g004 Nanomaterials 10 00542 g004

Green Silver Nanoparticles Formed by Phyllanthus urinaria, Pouzolzia zeylanica, and Scoparia dulcis Leaf Extracts and the Antifungal Activity
Abstract
1. Introduction
2. Materials and Methods
2.1. Materials
2.2. Preparation of Silver Nanoparticles Using P. urinaria, P. zeylanica, and S. dulcis Leaf Extracts
2.3. Characterization of Silver Nanoparticles
2.4. Antifungal Assays
2.5. Statistical Analysis
3. Results and Discussion
3.1. Biosynthesis of Silver Nnanoparticles from Plant Extracts
3.2. Size and Morphology of Biosynthesized Silver Nanoparticles (P.uri.AgNPs, P.zey.AgNPs and S.dul.AgNPs)
3.3. Antifungal Activities of P.uri.AgNPs, P.zey.AgNPs and S.dul.AgNPs
4. Conclusions
Supplementary Materials
Author Contributions
Acknowledgments
Conflicts of Interest
References
- Jamkhande, P.G.; Ghule, N.W.; Bamer, A.H.; Kalaskar, M.G. Metal nanoparticles synthesis: An overview on methods of preparation, advantages and disadvantages, and applications. J. Drug Deliv. Sci. Technol. 2019, 53, 101174. [Google Scholar] [CrossRef]
- Gellé, A.; Moores, A. Plasmonic nanoparticles: Photocatalysts with a bright future. Curr. Opin. Green Sustain. Chem. 2019, 15, 60–66. [Google Scholar] [CrossRef]
- Srivastava, V.; Gusain, D.; Sharma, Y.C. Critical Review on the Toxicity of Some Widely Used Engineered Nanoparticles. Ind. Eng. Chem. Res. 2015, 54, 6209–6233. [Google Scholar] [CrossRef]
- Narayanan, K.B.; Sakthivel, N. Biological synthesis of metal nanoparticles by microbes. Adv. Colloid Interface Sci. 2010, 156, 1–13. [Google Scholar] [CrossRef]
- Medici, S.; Peana, M.; Nurchi, V.M.; Zoroddu, M.A. Medical Uses of Silver: History, Myths, and Scientific Evidence. J. Med. Chem. 2019, 62, 5923–5943. [Google Scholar] [CrossRef]
- Grace, J.L.; Huang, J.X.; Cheah, S.-E.; Truong, N.P.; Cooper, M.A.; Li, J.; Davis, T.P.; Quinn, J.F.; Velkov, T.; Whittaker, M.R. Antibacterial low molecular weight cationic polymers: Dissecting the contribution of hydrophobicity, chain length and charge to activity. RSC Adv. 2016, 6, 15469–15477. [Google Scholar] [CrossRef]
- Barbon, S.M.; Truong, N.P.; Elliott, A.G.; Cooper, M.A.; Davis, T.P.; Whittaker, M.R.; Hawker, C.J.; Anastasaki, A. Elucidating the effect of sequence and degree of polymerization on antimicrobial properties for block copolymers. Polym. Chem. 2020, 11, 84–90. [Google Scholar] [CrossRef]
- Grace, J.L.; Elliott, A.G.; Huang, J.X.; Schneider, E.K.; Truong, N.P.; Cooper, M.A.; Li, J.; Davis, T.P.; Quinn, J.F.; Velkov, T.; et al. Cationic acrylate oligomers comprising amino acid mimic moieties demonstrate improved antibacterial killing efficiency. J. Mater. Chem. B 2017, 5, 531–536. [Google Scholar] [CrossRef]
- Elbourne, A.; Cheeseman, S.; Atkin, P.; Truong, N.P.; Syed, N.; Zavabeti, A.; Mohiuddin, M.; Esrafilzadeh, D.; Cozzolino, D.; McConville, C.F.; et al. Antibacterial Liquid Metals: Biofilm Treatment via Magnetic Activation. ACS Nano 2020, 14, 802–817. [Google Scholar] [CrossRef]
- Hoang Thi, T.T.; Lee, Y.; Le Thi, P.; Park, K.D. Nitric oxide-releasing injectable hydrogels with high antibacterial activity through in situ formation of peroxynitrite. Acta Biomater. 2018, 67, 66–78. [Google Scholar] [CrossRef]
- Akhtar, M.S.; Panwar, J.; Yun, Y.-S. Biogenic Synthesis of Metallic Nanoparticles by Plant Extracts. ACS Sustain. Chem. Eng. 2013, 1, 591–602. [Google Scholar] [CrossRef]
- Duan, H.; Wang, D.; Li, Y. Green chemistry for nanoparticle synthesis. Chem. Soc. Rev. 2015, 44, 5778–5792. [Google Scholar] [CrossRef] [PubMed]
- Hoseinpour, V.; Ghaemi, N. Green synthesis of manganese nanoparticles: Applications and future perspective—A review. J. Photochem. Photobiol. B Biol. 2018, 189, 234–243. [Google Scholar] [CrossRef] [PubMed]
- Roy, A.; Bulut, O.; Some, S.; Mandal, A.K.; Yilmaz, M.D. Green synthesis of silver nanoparticles: Biomolecule-nanoparticle organizations targeting antimicrobial activity. RSC Adv. 2019, 9, 2673–2702. [Google Scholar] [CrossRef]
- Ovais, M.; Khalil, A.T.; Raza, A.; Khan, M.A.; Ahmad, I.; Islam, N.U.; Saravanan, M.; Ubaid, M.F.; Ali, M.; Shinwari, Z.K. Green synthesis of silver nanoparticles via plant extracts: Beginning a new era in cancer theranostics. Nanomed. Nanotechnol. Biol. Med. 2016, 11, 3157–3177. [Google Scholar] [CrossRef]
- Hoang Thi, T.T.; Pilkington, E.H.; Nguyen, D.H.; Lee, J.S.; Park, K.D.; Truong, N.P. The Importance of Poly(ethylene glycol) Alternatives for Overcoming PEG Immunogenicity in Drug Delivery and Bioconjugation. Polymers 2020, 12, 298. [Google Scholar] [CrossRef]
- Ali, J.; Ali, N.; Wang, L.; Waseem, H.; Pan, G. Revisiting the mechanistic pathways for bacterial mediated synthesis of noble metal nanoparticles. J. Microbiol. Methods 2019, 159, 18–25. [Google Scholar] [CrossRef]
- Sathiyanarayanan, G.; Dineshkumar, K.; Yang, Y.H. Microbial exopolysaccharide-mediated synthesis and stabilization of metal nanoparticles. Crit. Rev. Microbiol. 2017, 43, 731–752. [Google Scholar] [CrossRef]
- Pulit, J.; Banach, M.; Zielina, M.; Laskowska, B.; Kurleto, K. Raspberry Extract as Both a Stabilizer and a Reducing Agent in Environmentally Friendly Process of Receiving Colloidal Silver. J. Nanomater. 2013, 2013, 1–12. [Google Scholar] [CrossRef]
- Pulit, J.; Banach, M. Preparation of nanosilver and nanogold based on dog rose aqueous extract. Bioinorg. Chem. Appl. 2014, 2014, 658935. [Google Scholar] [CrossRef]
- Pulit-Prociak, J.; Banach, M. The Use of Plant Materials in the Process of Obtaining Silver and Gold Nanoparticles. J. Comput. Theor. Nanosci. 2016, 13, 2697–2704. [Google Scholar] [CrossRef]
- Hossain, M.S.; Rahman, M.S.; Imon, A.H.M.R.; Zaman, S.; Siddiky, A.S.M.B.A.; Mondal, M.; Sarwar, A.; Huq, T.B.; Adhikary, B.C.; Begum, T.; et al. Ethnopharmacological investigations of methanolic extract of Pouzolzia Zeylanica (L.) Benn. Clin. Phytosci. 2016, 2. [Google Scholar] [CrossRef]
- Chen, X.-M.; Li, Z.-H.; Tao, S.-H.; Chen, Y.-F.; Chen, Z.-H.; Guo, L.-B. Effect of FPZ, a total flavonoids ointment topical application from Pouzolzia zeylanica var. microphylla, on mice skin infections. Rev. Brasil. Farmacogn. 2018, 28, 732–737. [Google Scholar] [CrossRef]
- Geethangili, M.; Ding, S.-T. A Review of the Phytochemistry and Pharmacology of Phyllanthus urinaria L. Front. Pharmacol. 2018, 9, 1109. [Google Scholar] [CrossRef]
- Choudhury, H.; Pandey, M.; Hua, C.K.; Mun, C.S.; Jing, J.K.; Kong, L.; Ern, L.Y.; Ashraf, N.A.; Kit, S.W.; Yee, T.S.; et al. An update on natural compounds in the remedy of diabetes mellitus: A systematic review. J. Tradit. Complement. Med. 2018, 8, 361–376. [Google Scholar] [CrossRef]
- Seyed, M.A. A comprehensive review on Phyllanthus derived natural products as potential chemotherapeutic and immunomodulators for a wide range of human diseases. Biocatal. Agric. Biotechnol. 2019, 17, 529–537. [Google Scholar] [CrossRef]
- Liu, Q.; Yang, Q.M.; Hu, H.J.; Yang, L.; Yang, Y.B.; Chou, G.X.; Wang, Z.T. Bioactive diterpenoids and flavonoids from the aerial parts of Scoparia dulcis. J. Nat. Prod. 2014, 77, 1594–1600. [Google Scholar] [CrossRef]
- Frezza, C.; Venditti, A.; Toniolo, C.; De Vita, D.; Franceschin, M.; Ventrone, A.; Tomassini, L.; Foddai, S.; Guiso, M.; Nicoletti, M.; et al. Nor-Lignans: Occurrence in Plants and Biological Activities—A Review. Molecules 2020, 25, 197. [Google Scholar] [CrossRef]
- Vo, Q.H.; Nguyen, P.H.; Zhao, B.T.; Ali, M.Y.; Choi, J.S.; Min, B.S.; Nguyen, T.H.; Woo, M.H. Protein tyrosine phosphatase 1B (PTP1B) inhibitory constituents from the aerial parts of Tradescantia spathacea Sw. Fitoterapia 2015, 103, 113–121. [Google Scholar] [CrossRef]
- Meera, P.; Kavitha, V.; Krishnaja, K.R. Scoparia dulcis: A review on its phytochemical and pharmacological profile. Innorig. Int. J. Sci. 2017, 4, 18–22. [Google Scholar]
- Silver Nanoparticles: Optical Properties. Available online: https://nanocomposix.eu/pages/silver-nanoparticles-optical-properties (accessed on 20 February 2020).
- Singh, M.; Sinha, I.; Mandal, R.K. Role of pH in the green synthesis of silver nanoparticles. Mater. Lett. 2009, 63, 425–427. [Google Scholar] [CrossRef]
- Ahsan, M.; Islam, S.N.; Gray, A.I.; Stimson, W.H. Cytotoxic Diterpenes from Scoparia dulcis. J. Nat. Prod. 2003, 66, 958–961. [Google Scholar] [CrossRef] [PubMed]
- Amini, S.M. Preparation of antimicrobial metallic nanoparticles with bioactive compounds. Mater. Sci. Eng. C 2019, 103, 109809. [Google Scholar] [CrossRef] [PubMed]
- Bhattarai, B.; Zaker, Y.; Bigioni, T.P. Green synthesis of gold and silver nanoparticles: Challenges and opportunities. Curr. Opin. Green Sustain. Chem. 2018, 12, 91–100. [Google Scholar] [CrossRef]
- Madkour, M.; Bumajdad, A.; Al-Sagheer, F. To what extent do polymeric stabilizers affect nanoparticles characteristics? Adv. Coll. Interface Sci. 2019, 270, 38–53. [Google Scholar] [CrossRef]
- Buzea, C.; Pacheco, I.I.; Robbie, K. Nanomaterials and nanoparticles: Sources and toxicity. Biointerphases 2007, 2, MR17. [Google Scholar] [CrossRef]

| Symbolization | Description |
|---|---|
| P.uri.AgNP15 | 15 ppm of P.uri.AgNPs in PDA |
| P.uri.AgNP30 | 30 ppm of P.uri.AgNPs in PDA |
| P.uri.AgNP45 | 45 ppm of P.uri.AgNPs in PDA |
| P.zey.AgNP15 | 15 ppm of P.zey.AgNPs in PDA |
| P.zey.AgNP30 | 30 ppm of P.zey.AgNPs in PDA |
| P.zey.AgNP45 | 45 ppm of P.zey.AgNPs in PDA |
| S.dul.AgNP15 | 15 ppm of S.dul.AgNPs in PDA |
| S.dul.AgNP30 | 30 ppm of S.dul.AgNPs in PDA |
| S.dul.AgNP45 | 45 ppm of S.dul.AgNPs in PDA |
© 2020 by the authors. Licensee MDPI, Basel, Switzerland. This article is an open access article distributed under the terms and conditions of the Creative Commons Attribution (CC BY) license (http://creativecommons.org/licenses/by/4.0/).
Share and Cite
Nguyen, D.H.; Lee, J.S.; Park, K.D.; Ching, Y.C.; Nguyen, X.T.; Phan, V.H.G.; Hoang Thi, T.T. Green Silver Nanoparticles Formed by Phyllanthus urinaria, Pouzolzia zeylanica, and Scoparia dulcis Leaf Extracts and the Antifungal Activity. Nanomaterials 2020, 10, 542. https://doi.org/10.3390/nano10030542
Nguyen DH, Lee JS, Park KD, Ching YC, Nguyen XT, Phan VHG, Hoang Thi TT. Green Silver Nanoparticles Formed by Phyllanthus urinaria, Pouzolzia zeylanica, and Scoparia dulcis Leaf Extracts and the Antifungal Activity. Nanomaterials. 2020; 10(3):542. https://doi.org/10.3390/nano10030542
Chicago/Turabian StyleNguyen, Dai Hai, Jung Seok Lee, Ki Dong Park, Yern Chee Ching, Xuan Thi Nguyen, V.H. Giang Phan, and Thai Thanh Hoang Thi. 2020. "Green Silver Nanoparticles Formed by Phyllanthus urinaria, Pouzolzia zeylanica, and Scoparia dulcis Leaf Extracts and the Antifungal Activity" Nanomaterials 10, no. 3: 542. https://doi.org/10.3390/nano10030542
APA StyleNguyen, D. H., Lee, J. S., Park, K. D., Ching, Y. C., Nguyen, X. T., Phan, V. H. G., & Hoang Thi, T. T. (2020). Green Silver Nanoparticles Formed by Phyllanthus urinaria, Pouzolzia zeylanica, and Scoparia dulcis Leaf Extracts and the Antifungal Activity. Nanomaterials, 10(3), 542. https://doi.org/10.3390/nano10030542

